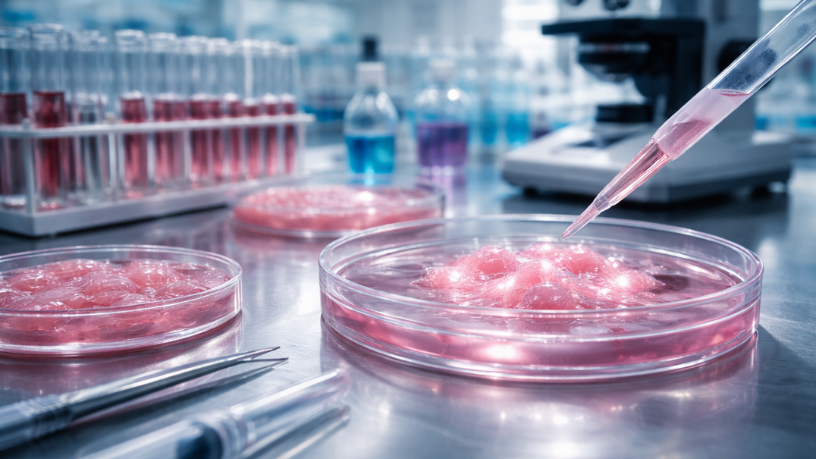
O uso de células-tronco na cirurgia plástica exige análise de evidência científica, conforme esclarece Milton Seigi Hayashi.

O médico cirurgião plástico Milton Seigi Hayashi atua em uma área em que ciência, tecnologia e expectativa do paciente se encontram, e nem sempre com a mesma velocidade. Nos últimos anos, o termo células-tronco passou a circular com força em conteúdos sobre rejuvenescimento, cicatrização e reconstrução, muitas vezes com promessas amplas e pouca explicação sobre o que é comprovado, o que é promissor e o que ainda não passou por validação adequada.
Ao longo deste artigo, você vai entender como esse tema é tratado na literatura médica, quais aplicações têm melhor sustentação científica, quais pontos exigem cautela e por que a diferença entre pesquisa e tratamento disponível é essencial. Se você quer informação clara, técnica e aplicável, siga a leitura.
O que o termo células-tronco realmente significa no contexto da cirurgia plástica?
Na prática, células-tronco são células com capacidade de se diferenciar e participar de processos de reparo tecidual, mas o uso do termo no dia a dia é frequentemente impreciso. Em cirurgia plástica, é comum que discussões envolvem tecidos como o adiposo, que contém diferentes populações celulares e componentes biológicos associados a regeneração, inflamação e cicatrização. Isso não significa, automaticamente, que qualquer procedimento com gordura ou com derivados do tecido adiposo seja terapia com células-tronco.
O ponto central é separar a linguagem de marketing de linguagem científica. Quando se fala em terapias celulares, entram em jogo padronização de preparo, segurança, indicação e evidência clínica. A mesma expressão pode estar sendo usada para descrever desde estratégias de reparo tecidual em investigação até abordagens ainda sem aprovação e sem protocolos consistentes. É aqui que a orientação técnica do Milton Seigi Hayashi ganha valor: traduzir conceitos sem simplificar demais.
Quais aplicações têm base mais sólida na literatura e na prática clínica?
Alguns campos são naturalmente mais propensos a pesquisa e evolução, como cicatrização, qualidade de pele e reconstruções. A literatura inclui estudos avaliando componentes do tecido adiposo e seus efeitos em cicatrização e reparo, com diferentes metodologias e resultados, informa Hayashi. O que se observa é que existe racional biológico plausível para investigar o papel dessas células e mediadores no processo de regeneração, mas plausibilidade não é sinônimo de indicação irrestrita.
Quando a evidência é mais consistente, ela tende a ser descrita com limites claros: população estudada, método de preparo, critérios de segurança e desfechos objetivos. Em termos práticos, isso significa que o paciente deve desconfiar de promessas universais. Resultados variam conforme técnica, biologia individual, qualidade do pós-operatório e, principalmente, conforme o que está sendo aplicado de fato. A boa medicina é aquela que comunica benefícios potenciais sem omitir incertezas.
@miltonseigihayashCirurgia plástica em 3D: visão de Milton Seigi Hayashi sobre planejamento avançado Milton Seigi Hayashi explora como a tecnologia 3D está redefinindo o planejamento cirúrgico, permitindo cirurgias mais seguras, detalhadas e personalizadas. Neste vídeo, ele apresenta casos práticos, benefícios clínicos e como o 3D contribui para resultados mais previsíveis e satisfatórios na cirurgia plástica. #MiltonSeigiHayashi #QuemÉMiltonSeigiHayashi #OQueAconteceuComMiltonSeigiHayashi #MédicoMiltonSeigiHayashi #CirurgiãoPlásticoMiltonSeigiHayashi
♬ som original – Milton Seigi Hayashi – Milton Seigi Hayashi
O que ainda é experimental e por que isso importa para o paciente?
Chama-se experimental aquilo que ainda depende de validação clínica robusta, reprodutibilidade e segurança demonstrada em protocolos padronizados. Em terapias celulares, esse critério é particularmente importante porque pequenas variações de processamento, concentração e forma de aplicação podem alterar riscos e resultados. Além disso, a distância entre um achado promissor e um tratamento recomendado pode ser grande, justamente porque a medicina precisa comprovar mais do que efeito, precisa comprovar segurança e consistência.
Para o paciente, isso importa por um motivo simples: decisões baseadas em hype aumentam o risco de frustração e, em cenários piores, de complicações. Por isso, o papel do especialista é organizar a expectativa. Milton Seigi Hayashi pode abordar esse tema com clareza ao explicar que medicina regenerativa séria não vende atalhos, ela constrói evidências, compara técnicas e reconhece limitações.
Como avaliar se um tratamento é sério, seguro e adequado para o seu caso?
A avaliação começa pela consulta bem conduzida e por um plano que conecte indicação, expectativa e risco. O paciente deve buscar clareza sobre qual técnica será utilizada, quais resultados são realistas e quais evidências sustentam aquela proposta. Em temas ligados à regeneração, é essencial entender o que será aplicado, se há padronização, quais são as alternativas e como o acompanhamento pós-operatório será conduzido.
O futuro tende a consolidar abordagens mais precisas, combinando cirurgia, biomateriais, engenharia tecidual e terapias celulares dentro de trilhas mais bem definidas. No entanto, esse futuro não se constrói com promessas genéricas, e sim com pesquisa, revisões críticas e prática responsável. Ao tratar dessas fronteiras com linguagem acessível e técnica, Milton Seigi Hayashi contribui para um paciente mais bem informado, com escolhas mais seguras e alinhadas à medicina baseada em evidências.
Autor: Diego Velázquez





